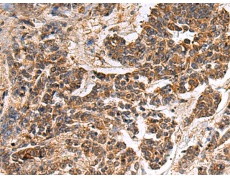
一抗

|
Background: |
Together with the cullin protein ANAPC2, constitutes the catalytic component of the anaphase promoting complex/cyclosome (APC/C), a cell cycle-regulated E3 ubiquitin ligase that controls progression through mitosis and the G1 phase of the cell cycle. The APC/C complex acts by mediating ubiquitination and subsequent degradation of target proteins: it mainly mediates the formation of 'Lys-11'-linked polyubiquitin chains and, to a lower extent, the formation of 'Lys-48'- and 'Lys-63'-linked polyubiquitin chains. May recruit the E2 ubiquitin-conjugating enzymes to the complex. |
|
Applications: |
ELISA, IHC |
|
Name of antibody: |
GANAB |
|
Immunogen: |
Synthetic peptide of human GANAB |
|
Full name: |
anaphase promoting complex subunit 11 |
|
Synonyms: |
APC11; Apc11p; HSPC214 |
|
SwissProt: |
Q14697 |
|
ELISA Recommended dilution: |
5000-10000 |
|
IHC positive control: |
Human gastric cancer and human lung cancer |
|
IHC Recommend dilution: |
25-100 |


 購物車
購物車 幫助
幫助
 021-54845833/15800441009
021-54845833/15800441009